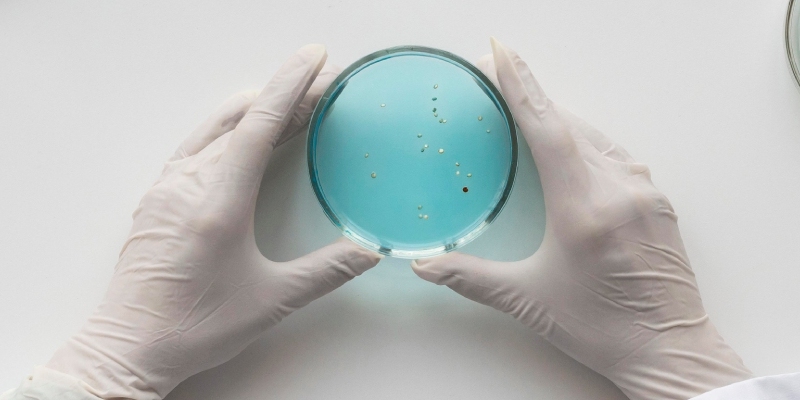
clostridium perfringens

La bacteria Clostridium perfringens es una importante causa de toxiinfecciones alimentarias. La Asociación Española de Normalización, UNE, ha publicado una nueva norma en la que se especifica el método horizontal para el recuento de C. perfringens mediante la técnica de recuento de colonias, que es aplicable a una amplia gama de alimentos.
Clostridium perfringens en alimentos
Clostridium perfringens es una bacteria relevante para la salud pública por ser el origen intoxicaciones alimentarias, que puede encontrarse en una una variedad de alimentos, en particular aquellos que se preparan en grandes cantidades y se mantienen calientes listos para el consumo durante un largo período de tiempo antes de servir.
Clostridium perfringens puede formar esporas altamente resistentes al calor, que pueden sobrevivir a la cocción, y germinar y multiplicarse en los alimentos después del proceso de cocción.
Una elevada presencia de C. perfringens en los alimentos puede ser un indicio de preparación o manipulación inadecuada de los mismos. No mantener las temperaturas adecuadas de cocinado, refrigeración, almacenamiento y recalentado de los alimentos, junto con unas malas prácticas de higiene de manos y superficies pueden favorecer la contaminación y el crecimiento de la bacteria hasta niveles de riesgo.
Las cepas de la bacteria se clasifican dependiendo de la capacidad de producir diferentes tipos de toxinas. Las intoxicaciones alimentarias en humanos son causadas principalmente por aislados de C. perfringens con capacidad de producir la enterotoxina de C. perfringens (CPE), que se produce en el intestino durante la esporulación.
La Asociación Española de Normalización, UNE, ha publicado la segunda parte de la norma ISO 15213, en la que se describe el método horizontal para el recuento de C. perfringens en alimentos, piensos, muestras ambientales y muestras de la etapa de producción primaria. Esta norma es la versión oficial, en español, de la Norma Europea EN ISO 15213-2:2023, y anula y sustituye a la Norma UNE-EN ISO 7937:2005.
UNE-EN ISO 15213-2
Microbiología de la cadena alimentaria
Método horizontal para la detección y recuento de Clostridium spp.
Parte 2: Recuento de Clostridium perfringens mediante la técnica de recuento de colonias
(ISO 15213-2:2023)
Los principales cambios técnicos que introduce esta norma son:
- se amplia el objeto y campo de aplicación a muestras de la etapa de producción primaria
- se hace opcional el tratamiento térmico de 10 min a 80 °C, en el caso de abundante flora interfiriente o para el recuento únicamente de esporas de Clostridium (C.) perfringens presentes en la muestra
- se renombra el medio selectivo agar sulfito-cicloserina (SC) a agar triptosa sulfito-cicloserina (agar TSC) sin cambios en la formulación
- se modifican los métodos de confirmación descritos según la Norma ISO 14189
- se revisa el diagrama de flujo del anexo normativo A, que ofrece una breve descripción del procedimiento
- se añaden criterios para los ensayos de rendimiento de los medios de cultivo en el anexo B
- se añaden las características de funcionamiento en el anexo C (informativo)
- en el anexo D (informativo), se añaden dos métodos moleculares para la diferenciación entre C. perfringens patógeno y no patógeno y un método molecular para la diferenciación de cepas de C. perfringens tipo A que poseen un gen cpe codificado cromosómicamente, de las que llevan un gen cpe codificado en un plásmido.
Campo de aplicación
La norma UNE-EN ISO 15213-2 especifica el recuento de Clostridium (C.) perfringens mediante la técnica de recuento de colonias en:
- productos destinados al consumo humano
- productos para la alimentación de animales
- muestras medioambientales en el ámbito de la producción y manipulación de alimentos y piensos
- muestras de la etapa de producción primaria.
Este método ha sido validado en un estudio interlaboratorios para las siguientes categorías de alimentos:
- productos cárnicos listos para el consumo y listos para recalentar
- huevos y ovoproductos (derivados)
- frutas y hortalizas procesadas
- leche y cereales para lactantes
- alimentos o comidas con múltiples componentes.
También ha sido validado para las siguientes otras categorías:
- piensos para mascotas y animales
- muestras ambientales (producción de alimentos o piensos).
Podéis encontrar más información y/o adquirir esta norma en la web de la Asociación Española de Normalización, UNE.